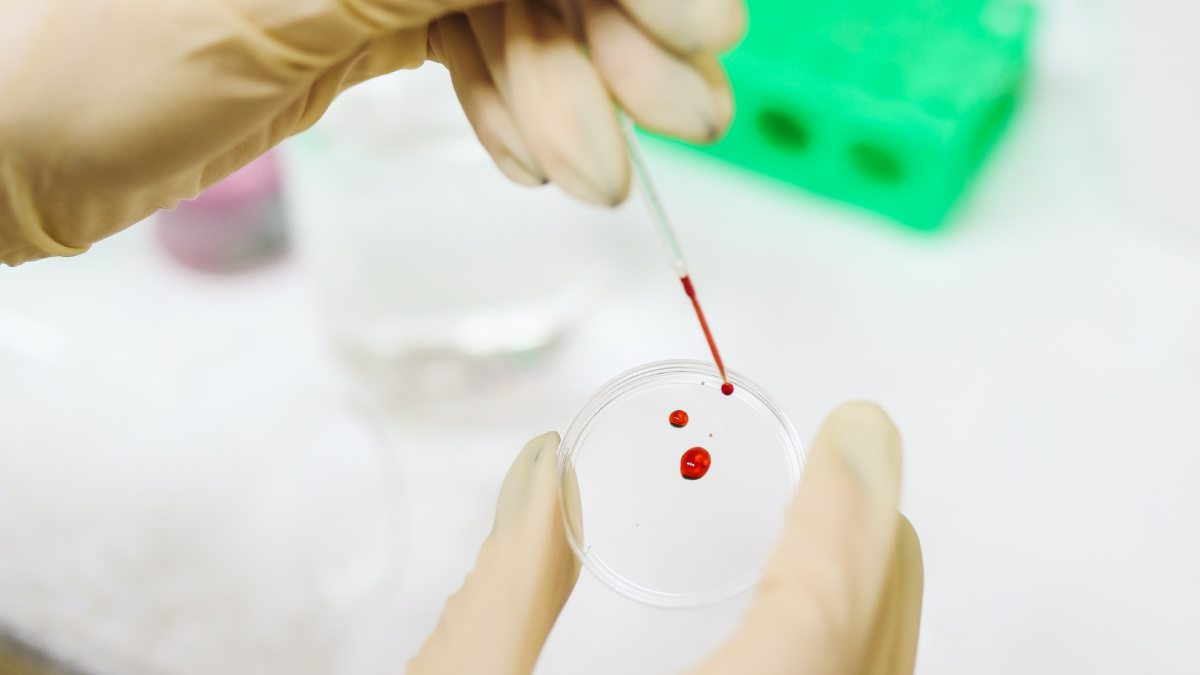
Image of blood test Image of blood test

অ্যানিমিয়া বা রক্তাল্পতা কী, কারি পাতা খেলে কি এই রোগ থেকে মুক্তি মিলবে?
রক্তাল্পতা বা অ্যানিমিয়া এই রোগটির সঙ্গে আমরা সকলেই প্রায় কম বেশি পরিচিত বা এই রোগের নাম হয়তো অনেকেই জানেন। এটি একটি ভয়ংকর রোগ। রক্তে লোহিত কণিকা বা হিমোগ্লোবিনের পরিমাণ বেড়ে গেলেই মূলত অ্যানিমিয়া রোগের সৃষ্টি হয়। বলা হয় রক্তের মধ্যে হিমোগ্লোবিনের পরিমাণ যদি স্বাভাবিক মাত্রার থেকে কমে যায় তাহলে কিন্তু রক্তাল্প্রতার শিকার হন সেই ব্যক্তি।
ক্লান্তি, দুর্বলতা হল অ্যানিমিয়ার প্রধান লক্ষণ। এছাড়াও এমন অনেক লক্ষণ রয়েছে যা জানলে অবাক হবেন আপনিও। শ্বাসকষ্ট, মাঝেমধ্যে মাথা ঘোরা, মাথা ব্যথা, হাত পা ঠান্ডা হয়ে আসা, শরীর ফ্যাকাশে হয়ে আসা, বুকে ব্যথা অনুভব হওয়া এই রোগের একটি প্রধান লক্ষণ। রক্ত পরীক্ষা করলে এই রোগ খুব সহজেই ধরা পড়ে। তবে ভালো খাওয়া দাওয়া এবং ডাক্তারি ওষুধের মাধ্যমে সুস্থ হওয়া যায়। তবে এটি খুব খারাপ এক ধরনের রোগ।
এমন অনেক খাবার হয়েছে যেগুলো যদি আপনি নিত্যদিন খান তাহলে কিন্তু আপনি কখনোই অ্যানিমিয়া হবে না, তেমনই কারি পাতা খাওয়া শরীরের জন্য খুব ভালো। এটি খেলে অ্যানিমিয়া থেকে মুক্তি পাবেন।
কারি পাতা এটি একটি ভেষজ পাতা হিসেবে ধরা হয়। এটি প্রায় প্রত্যেকের বাড়িতেই কম বেশি থাকে। এই পাতাটি খেতে সামান্য মিষ্টি মিষ্টি। এই কারি পাতা যারা খান তাদের অনেক রোগ কিন্তু হয় না। এটা আমরা রান্নায় মশলা হিসেবে ব্যবহার করে থাকি। এটি খেলে আপনার অ্যানিমিয়া কোনভাবেই হবে না বা যাদের অ্যানিমিয়া রয়েছে তারা কিন্তু সুস্থ হবার জন্য এই কারি পাতা নিত্যদিন খেতে পারেন।

কারি পাতা খেলে রক্তশূন্যতা দূর হয়। খাদ্য তালিকায় রোজ রাখুন কারি পাতা। কারণ এটিতে প্রচুর পরিমাণে ক্যালসিয়াম, আয়রণ এবং জিঙ্ক রয়েছে। যা অ্যানিমিয়ার বিরুদ্ধে লড়াই করে।
যাদের ত্বকের সমস্যা রয়েছে তারা কিন্তু কারি পাতা খেতে পারেন। এটি খেলে আপনার ত্বকের নানান সমস্যা দূর হবে। সেই সঙ্গে ত্বক হবে উজ্জ্বল। ত্বকের হলদেটে ভাব কেটে যাবে, যারা কারি পাতা প্রচুর পরিমাণে খান তাদের পুষ্টির ঘাটতি পূরণ হয়। এটি আপনার ত্বকের তৈলাক্ত ভাব কমাবে এবং আপনার ত্বকের কখনোই হতে দেবে না শুক্ষ। সেই সঙ্গে আপনি সুস্থও থাকতে পারবেন।

এমন অনেক ব্যক্তি রয়েছেন যাদের শরীরে আয়রনের ঘাটতি রয়েছে, তারা যদি আয়রনের ঘাটতি পূরণ করতে চান তাহলে কারি পাতা নিত্যদিন রান্নায় দিয়ে খেতে পারেন। কারি পাতা আপনার ত্বক যেমন সুস্থ রাখবেন তেমনি এটিতে ফলিক অ্যাসিড রয়েছে। এটি আপনার আয়রনের মাত্রা শরীরে বাড়াবে। কারি পাতা খেতেও কিন্তু খুব সুন্দর। রান্নায় দিলে এর স্বাদও কিন্তু একটু বাড়ে।
অনেকেরই কিন্তু মুখে আলসার হয়। ছোট ছোট সাদা ঘাকেই কিন্তু আলসার বলা হয়। এই আলসার কিন্তু শরীরের জন্য খুব খারাপ। যদি এই আলসারকে আপনি কমাতে চান তাহলে নিত্যদিন খাদ্য তালিকায় কারিপাতায় রাখতে পারেন। মধুর সঙ্গে কারি পাতার গুঁড়ো মিশিয়ে মুখের আলসারে লাগাতে পারেন, দু-তিন দিনের মধ্যে এটি থেকে আপনি সুস্থ হবেন।












Click it and Unblock the Notifications